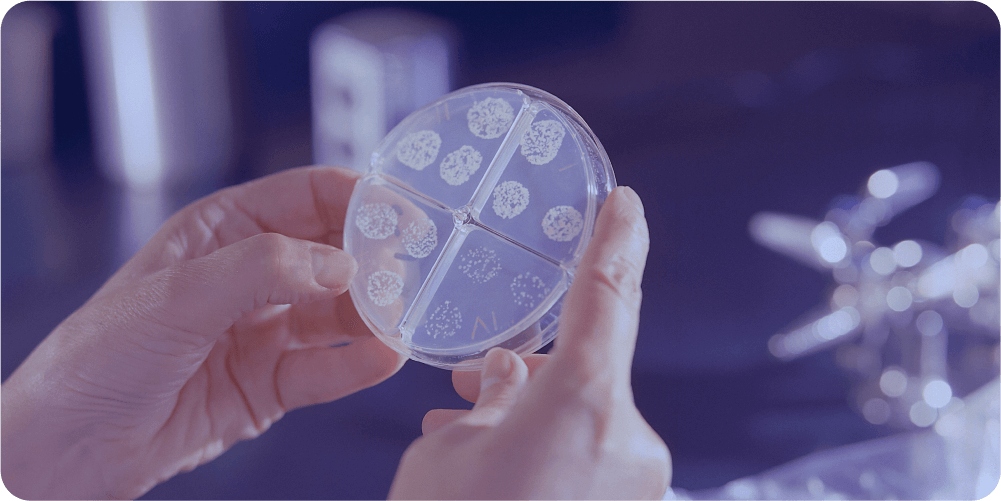
Руки держат чашку Петри с небольшими круглыми бактериальными культурами, разделёнными на четыре секции. Сцена создаёт научную и сосредоточенную атмосферу.

Типы и стадии рака
Стадия болезни определяется в зависимости от размера опухоли, от того, есть ли опухолевые клетки в лимфатических узлах и метастазы в других органах.
В зависимости от распространенности рак может быть преинвазивным (in situ) — очень маленькая опухоль, которая не успела прорасти в кровеносную систему и которая не требует никакого лечения, кроме удаления.
Или инвазивным (in situ) — когда опухоль уже начала прорастать, а значит, могла дать метастазы.
От вида рака напрямую зависит и лечение. Чаще всего речь идет о молекулярной таксономии и выделяют 4 подтипа:
- Люминальный подтип A (30—45 %): эстроген-зависимые малоагрессивные опухоли, избытка экспрессии рецепторов белка HER2 нет;
- Люминальный подтип B (14—18 %): эстроген-зависимые агрессивные опухоли, выражена амплификация онкогена HER2;
- HER2-позитивный подтип (8—15 %): эстроген-независимые агрессивные опухоли, выражена амплификация онкогена HER2;
- «Triple negative» подтип (27—39 %): эстроген-независимые агрессивные опухоли, избытка экспрессии рецепторов белка HER2 нет.
Именно от этих подтипов чаще всего (за исключением редких видов) зависит протокол и стратегия лечения.
Чтобы финально определить стадию и тип рака, онколог назначает дополнительное обследование, которое может выявить региональные и отдаленные метастазы рака молочной железы: рентгенографию грудной клетки, осмотр гинеколога, УЗИ печени, надпочечников, яичников, щитовидной железы, развернутый анализ крови. При необходимости – компьютерную томографию, сканирование костей скелета, МРТ и др. — все очень индивидуально, каждый случай уникален.

